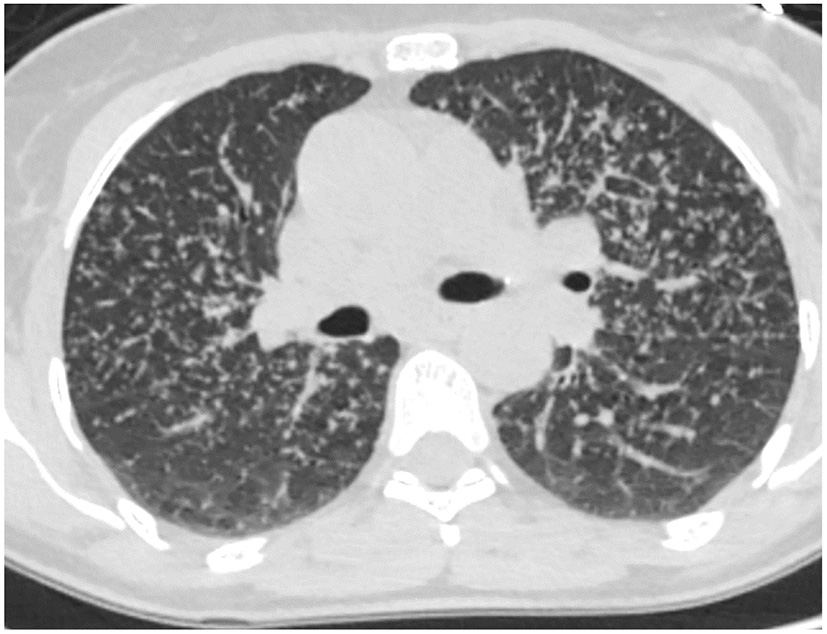
Figure 6

Abstract
In this article, we describe the role of radiology for diagnosis and follow-up of progressive fibrosing interstitial lung disease (PF-ILD). Patients with PF-ILD are at increased risk for early death without treatment. Clinical diagnosis of PF-ILD has been described in the literature. This manuscript reviews the radiographic diagnosis of PF-ILD and the unique CT characteristics associated with specific types of fibrosis. Ultimately, we believe that radiology has the potential to recognize progression early and thus make an important contribution to the multidisciplinary discussion for this important diagnosis.
Introduction
In broad terms, there are two types of interstitial lung diseases (ILDs); one of which is primarily inflammatory with the potential for complete resolution but with the possibility of transformation into a fibrotic phenotype, the other is a primarily fibrotic ILD and largely irreversible (1). The treatment of an inflammatory ILD is different from its fibrotic counterpart thus correct diagnosis has important implications. Progressive fibrosing interstitial lung disease (PF-ILD) is defined as a subtype of interstitial lung disease which advances despite current state of the art treatment and predicts a poor outcome (2). Inflammatory ILDs can transform to the progressive fibrotic type, which may then benefit from anti-fibrotic treatment strategies to slow the decline of forced vital capacity (FVC) (3).
Nintedanib is approved for treatment of idiopathic pulmonary fibrosis (IPF), and has demonstrated improved outcomes with diminished FVC decline compared to placebo in PF- ILD patients (3). The RELIEF study, a phase 2b trial, was terminated prematurely due to slow enrollment but found that adding pirfenidone to treatment regimen in patients with non-IPF slowed disease progression (4). Raghu warns that the use of a single agent to treat all progressive fibrotic lung diseases should not deter the clinician from evaluating the underlying cause as there may be specific interventions that could lead to improved patient outcomes (4). Defining this phenotype has implications that go beyond therapy with the opportunity for early referral to lung transplantation and/or the initiation of advanced care planning (5).
There is limited experience with the prevalence and incidence of the progressive phenotype of ILD (6). One source, which excluded IPF, estimates the progressive phenotype to be 13% to 40% depending on the underlying diagnosis (7). The diagnosis of progressive disease relies upon a decline in pulmonary function tests, progressive shortness of breath, and more extensive disease on imaging (2). In the INBUILD trial, which studied the effect of Nintedanib on the progressive phenotype, the criteria for progression were: 10% decrease of the predicted FVC, 5 to 10% decrease in predicted FVC with progressive dyspnea or increased radiographic fibrosis, or progressive dyspnea with increased radiographic fibrosis, all within 24 months prior to screening and despite conventional therapy (3). Regardless of how this term is defined, it is best established through a multidisciplinary discussion. Radiology plays a vital role in the diagnosis of the progressive phenotype by identifying increased pulmonary fibrosis. Collins et al. argue that the pattern and extent of fibrosis could affect clinical outcomes more than the diagnosis (8). The INBUILD criteria for progression were used in a retrospective study in the UK with 1,749 patients with ILD other than IPF. Two hundred and fifty three patients (14.5%) met the criteria for a progressive phenotype. This subset of patients had worse mortality compared to the non-progressive ILD and similar mortality to IPF (9). Other research papers have found similar results (10). The intent of our paper is to describe imaging features of the progressive phenotype of ILD. Ultimately a multidisciplinary discussion is necessary for the accurate diagnosis.
Usual Interstitial Pneumonitis (UIP)
The 2018 American thoracic society IPF guidelines provide four levels of confidence for UIP diagnosis. These include: UIP, probable UIP, indeterminate for UIP and a pattern suggesting alternative diagnosis. UIP is defined with sub pleural basilar predominant fibrosis, honeycombing, and the absence of features that would suggest another diagnosis. If there is no honeycombing, the pattern is a “probable UIP” pattern which previously was termed “possible UIP” (11).
UIP pattern on CT is often associated with the clinical diagnosis of idiopathic pulmonary fibrosis (IPF) that has a life expectancy of 3 to 4 years without treatment (12). Patients with a UIP pattern are more likely to be older in age, male gender, and smokers (13). This pattern carries a worse prognosis and an increased risk of death regardless of the underlying cause (14). More frequent acute exacerbations are also seen with a UIP pattern (15). It is worth mentioning that a UIP pattern does not automatically equal a diagnosis of IPF as other interstitial lung diseases can have this pattern on HRCT (16). Drug toxicity, collagen vascular disease and chronic hypersensitivity pneumonitis and familial pulmonary fibrosis can also present with this pattern (17, 18). Several signs may help differentiate UIP pattern associated with IPF from a UIP pattern of other etiologies, these include the straight-edge sign, anterior upper lobe sign, and exuberant honeycombing, which are more likely to denote an underlying connective tissue disease rather than IPF (19). Non-IPF ILD's, which usually have better survival than IPF, carry similar mortality to IPF if radiologic honeycombing is present (20).
Fibrosis of the lung increases the density of the lung which is measured by Hounsfield units (HU). On chest CT, the normal lung measures from −850HU. In contrast, fibrotic lung appears whiter on CT with HUs of approximately −500 HU. Analysis of extent of high density areas allows the radiologist to provide a visual quantification of the amount of fibrosis (21). A grading system can provide a visual quantification of fibrosis (22). Follow up imaging can be used to assess the extent of conversion of normal lung to fibrotic lung. Therefore, it follows that a person who has progressive fibrosis would have a rate of change greater than zero and there is the opportunity to differentiate rapid progressors from slow progressors.
Not all patients who progress with IPF increase their extent of disease. Some progress by changing from a probable UIP to a UIP pattern with the development of honeycombing (Figure 1). Previously we reviewed 103 patients with a working diagnosis of IPF, 68 had a probable UIP pattern on the initial CT, 47% progressed to a UIP pattern with honeycombing (HC) over 51 months, therefore having a progressive phenotype. Thirty five patients had HC on the initial CT scan of which 57% increased the extent of disease over 31 months, also progressive disease. Enlarged pulmonary artery and emphysema were associated with disease progression (22). Serial imaging is used to evaluate progression which is not necessarily discovered between the first and second HRCT scans. Serial CT scans have the added benefit of the early identification of lung cancer (23).
Figure 1

Change from probable UIP pattern to UIP pattern indicative of progressive fibrosis.
Not all patients with connective tissue disease have an NSIP pattern, some patients have a UIP pattern with exuberant honeycombing and the straight edge sign (Figure 2) which can also progress in extent over time (24).
Figure 2

Axial and coronal images with straight edge sign characteristic of a UIP pattern associated with CTD.
Nonspecific Interstitial Pneumonitis (NSIP)
NSIP is a homogeneous, lower lung predominant type of fibrosis typically associated with connective tissue disease (CTD) (25). People with an NSIP pattern are more likely to be younger, and female gender (13). It has an overall better prognosis with fewer exacerbations compared to UIP (26), the median survival is >9 years (13). The extent of disease can be measured visually and progression noted when the extent of normal lung decreases. The radiologists can also describe the progression from non-fibrotic cellular NSIP with its predominant ground-glass opacity to mixed cellular and fibrotic NSIP with ground glass opacities and bronchiectasis and eventually fibrotic NSIP with the resolution of the majority of ground glass and addition of honeycombing in some patients (Figure 3). In a study of 108 patients with a working diagnosis of CTD, the radiographic pattern of disease changed over time in 35%. Sixty-three percent of patients had increased extent of disease on CT over time (26). The progression from a cellular phenotype to fibrosis is an important radiographic observation and along with patients clinical status can define a progressive phenotype.
Figure 3

Evolution of scleroderma from a cellular NSIP pattern to a mixed cellular and fibrotic pattern with bronchiectasis over the course of 10 months consistent with progressive disease.
Biomarkers are medical signs which can be measured and used to diagnose disease (27). Radiology can function as a biomarker. In fibrotic NSIP, the lower lobe predominant scarring diminishes the volume of the inferior lung and displaces the major fissures posteriorly, more so than UIP, which is also a lower lobe predominant fibrotic disease. An increase in the amount of volume loss for this disease can be used in part to identify a progressive phenotype (28) (Figure 4).
Figure 4

Typically the right lower lobe anterior bronchus (yellow arrow) follows a horizontal course but in this patient it is displaced posteriorly by volume loss and fibrosis. The displacement of the bronchus can be followed to document disease progression.
Hypersensitivity Pneumonitis (HP)
Patients with prolonged inhaled antigen exposure are at risk for permanent scarring of the lung. Patients with this pattern are more likely to be females and non-smokers (29). The pathology demonstrates fibrosis along the airways which may be associated with poorly formed granulomas (29). The latest guidelines for HP diagnosis were set up by the ATS in 2020. Three categories of confidence for HP diagnosis were listed, typical HP, compatible with HP and indeterminate for HP (30). Typical HP shows features of lung infiltration, with either mosaic attenuation or ground glass opacifications, plus features of small airway disease, with either air trapping or indistinct centrilobular nodules. Both of these criteria must be diffuse in distribution. The guidelines simplified the radiographic diagnosis further into two subtypes, fibrotic and non-fibrotic. The fibrotic phenotype is associated with greater traction bronchiectasis, architectural distortion and volume loss. Just like NSIP and UIP, the extent of disease can increase and suggest progression. In addition, the stage of disease can evolve from mostly non-fibrotic ground glass opacities which may resolve with antigen removal to a fibrotic phase with predominantly bronchiectasis (Figure 5). The change in stage with increased fibrosis represent disease progression (31).
Figure 5

Evolution of hypersensitivity pneumonitis from non-fibrotic to fibrotic phenotype over a 39 month period.
Sarcoidosis
There are basically two main types of sarcoidosis, fibrotic and non-fibrotic (32). The non-fibrotic type of sarcoid has pulmonary nodules and lymphadenopathy (Figure 6). The major feature of the progression of the fibrotic type of disease is volume loss with tenting of the hemi-diaphragms. Fibrotic sarcoid primarily affects the posterior aspect of the upper lobes and as such displaces the right upper lobe bronchus (32). In particular, the radiologist can measure the angle between a line traversing the right upper lobe bronchus and a sagittal line connecting the sternum to the vertebral body. The angle is called the Right Upper Lobe Bronchus Angle (RUL-BA) (Figure 7). The angle increases with the fibrotic phase of the disease and can be used as a biomarker for disease progression (32).
Figure 6
Non-fibrotic sarcoidosis with pulmonary nodules in a peri-lymphatic distribution.
Figure 7

Stage 4 sarcoidosis is associated with progressive loss of volume of the upper lobes with displacement of the right upper lobe bronchus posteriorly as seen in this image.
Conclusion
Progressive fibrosing interstitial lung disease occurs in a subset of individuals whose interstitial lung disease progresses despite appropriate treatment. Radiology contributes to the accurate diagnosis of the progressive phenotype by recognizing increasing fibrosis over time (Table 1).
Table 1
|
General CT signs of
progression |
Specific CT signs of
progression |
|
|---|---|---|
| UIP | Increase extent of fibrosis | Probable UIP to UIP pattern |
| NSIP | Increase extent of fibrosis | Cellular to fibrotic pattern |
| CHP | Increase extent of fibrosis | Cellular to fibrotic pattern |
| Sarcoid | Increase extent of fibrosis | Nodular to fibrotic pattern |
Radiology features of progressive fibrotic interstitial lung disease.
Publisher's Note
All claims expressed in this article are solely those of the authors and do not necessarily represent those of their affiliated organizations, or those of the publisher, the editors and the reviewers. Any product that may be evaluated in this article, or claim that may be made by its manufacturer, is not guaranteed or endorsed by the publisher.
Statements
Author contributions
All authors listed have made a substantial, direct, and intellectual contribution to the work and approved it for publication.
Conflict of interest
MS: speaker, advisory board, and grant funding from Genentech and Boehringer Ingelheim. MP: speaker for Vindico Medical education and France Foundation and a consultant for Genentech and Boehringer Ingelheim and Paradigm Medical Communications and has received a research grant from Boehringer Ingelheim. The remaining authors declare that the research was conducted in the absence of any commercial or financial relationships that could be construed as a potential conflict of interest.
References
1.
Kolb M Vašáková M . The natural history of progressive fibrosing interstitial lung diseases. Respir Res. (2019) 20:57. 10.1186/s12931-019-1022-1
2.
George PM Spagnolo P Kreuter M Altinisik G Bonifazi M Martinez FJ et al . Progressive fibrosing interstitial lung disease: clinical uncertainties, consensus recommendations, research priorities. Lancet Respir Med. (2020) 8:925–34. 10.1016/S2213-2600(20)30355-6
3.
Flaherty KR Wells AU Cottin V Devaraj A Walsh S Inoue Y et al . Nintedanib in progressive fibrosing interstitial lung diseases. N Engl J Med. (2019) 381:1718–27. 10.1056/NEJMoa1908681
4.
Raghu G . Nintedanib in progressive fibrosing interstitial lung diseases. N Engl J Med. (2020) 382:779–80. 10.1056/NEJMc1917224
5.
De Sadeleer LJ Goos T Yserbyt J Wuyts WA . Towards the essence of progressiveness: bringing progressive fibrosing interstitial lung disease (PF-ILD) to the next stage. J Clin Med. (2020) 9:1722. 10.3390/jcm9061722
6.
Cottin V . Treatment of progressive fibrosing interstitial lung diseases: a milestone in the management of interstitial lung diseases. Eur Respir Rev. (2019) 28:190109. 10.1183/16000617.0109-2019
7.
Olson A Hartmann N Patnaik P Wallace L Schlenker-Herceg R Nasser M et al . Estimation of the prevalence of progressive fibrosing interstitial lung diseases: systematic literature review and data from a physician survey. Adv Ther. (2021) 38:854–67. 10.1007/s12325-020-01578-6
8.
Collins BF Raghu G . Antifibrotic therapy for fibrotic lung disease beyond idiopathic pulmonary fibrosis. Eur Respir Rev. (2019) 28:190022. 10.1183/16000617.0022-2019
9.
Simpson T Barratt SL Beirne P Chaudhuri N Crawshaw A Crowley LE et al . The burden of progressive fibrotic interstitial lung disease across the UK. Eur Respir J. (2021) 58:2100221. 10.1183/13993003.00221-2021
10.
Komatsu M Yamamoto H Kitaguchi Y Kawakami S Matsushita M Uehara T et al . Clinical characteristics of non-idiopathic pulmonary fibrosis, progressive fibrosing interstitial lung diseases: A single-center retrospective study. Medicine. (2021) 100:e25322. 10.1097/MD.0000000000025322
11.
Raghu G Remy-Jardin M Myers JL Richeldi L Ryerson CJ Lederer DJ et al . Diagnosis of idiopathic pulmonary fibrosis. An official ATS/ERS/JRS/ALAT clinical practice guideline. Am J Respir Crit Care Med. (2018) 198:e44–68.
12.
Raghu G Chen SY Yeh WS Maroni B Li Q Lee YC et al . Idiopathic pulmonary fibrosis in US Medicare beneficiaries aged 65 years and older: incidence, prevalence, and survival, 2001-11. Lancet Respir Med. (2014) 2:566–72. 10.1016/S2213-2600(14)70101-8
13.
Ebner L Christodoulidis S Stathopoulou T Geiser T Stalder O Limacher A et al . Meta-analysis of the radiological and clinical features of usual interstitial pneumonia (UIP) and nonspecific interstitial pneumonia (NSIP). PLoS ONE. (2020) 15:e0226084. 10.1371/journal.pone.0226084
14.
Wong AW Ryerson CJ Guler SA . Progression of fibrosing interstitial lung disease. Respir Res. (2020) 21:32. 10.1186/s12931-020-1296-3
15.
Kolb M Bondue B Pesci A Miyazaki Y Song JW Bhatt NY et al . Acute exacerbations of progressive-fibrosing interstitial lung diseases. Eur Respir Rev. (2018) 27:180071. 10.1183/16000617.0071-2018
16.
Wuyts WA Cavazza A Rossi G Bonella F Sverzellati N Spagnolo P . Differential diagnosis of usual interstitial pneumonia: when is it truly idiopathic?Eur Respir Rev. (2014) 23:308–19. 10.1183/09059180.00004914
17.
Aburto M Herráez I Iturbe D Jiménez-Romero A . Diagnosis of idiopathic pulmonary fibrosis: differential diagnosis. Med Sci (Basel). (2018) 6:73. 10.3390/medsci6030073
18.
Bennett D Mazzei MA Squitieri NC Bargagli E Refini RM Fossi A et al . Familial pulmonary fibrosis: Clinical and radiological characteristics and progression analysis in different high resolution-CT patterns. Respir Med. (2017) 126:75–83. 10.1016/j.rmed.2017.03.020
19.
Chung JH Landeras L . Probable UIP: What is the evidence that compels this classification and how is it different from the indeterminate category?Semin Roentgenol. (2019) 54:15–20. 10.1053/j.ro.2018.12.006
20.
Adegunsoye A Oldham JM Bellam SK Montner S Churpek MM Noth I et al . Computed tomography honeycombing identifies a progressive fibrotic phenotype with increased mortality across diverse interstitial lung diseases. Ann Am Thorac Soc. (2019) 16:580–8. 10.1513/AnnalsATS.201807-443OC
21.
Salvatore M Henschke CI Yip R Jacobi A Eber C Padilla M et al . JOURNAL CLUB: Evidence of interstitial lung disease on low-dose chest ct images: prevalence, patterns, and progression. AJR Am J Roentgenol. (2016) 206:487–94. 10.2214/AJR.15.15537
22.
Salvatore M Singh A Yip R Fevrier E Henschke CI Yankelevitz D et al . Progression of probable UIP and UIP on HRCT. Clin Imaging. (2019) 58:140–4. 10.1016/j.clinimag.2019.07.003
23.
Walsh S Devaraj A Enghelmayer JI Kishi K Silva RS Patel N et al . Role of imaging in progressive-fibrosing interstitial lung diseases. Eur Respir Rev. (2018) 27:180073. 10.1183/16000617.0073-2018
24.
Chung JH Cox CW Montner SM Adegunsoye A Oldham JM Husain AN et al . CT features of the usual interstitial pneumonia pattern: differentiating connective tissue disease-associated interstitial lung disease from idiopathic pulmonary fibrosis. AJR Am J Roentgenol. (2018) 210:307–13. 10.2214/AJR.17.18384
25.
Salvatore M Smith ML . Cross sectional imaging of pulmonary fibrosis translating pathology into radiology. Clin Imaging. (2018) 51:332–6. 10.1016/j.clinimag.2018.06.013
26.
Salvatore M Mathur M Fang Guo L O'Connor T Padilla M . Connective tissue disease and its evolution on chest CT. Curr Trends Clin Med Imaging. (2019) 3:555621. 10.19080/CTCMI.2019.03.555621
27.
Strimbu K Tavel JA . What are biomarkers?Curr Opin HIV AIDS. (2010) 5:463–6. 10.1097/COH.0b013e32833ed177
28.
Robbie H Wells AU Jacob J Walsh S Nair A Srikanthan A et al . Visual and automated CT measurements of lung volume loss in idiopathic pulmonary fibrosis. AJR Am J Roentgenol. (2019) 213:318–24. 10.2214/AJR.18.20884
29.
Magee AL Montner SM Husain A Adegunsoye A Vij R Chung JH . Imaging of hypersensitivity pneumonitis. Radiol Clin North Am. (2016) 54:1033–46. 10.1016/j.rcl.2016.05.013
30.
Raghu G Remy-Jardin M Ryerson CJ Myers JL Kreuter M Vasakova M et al . Diagnosis of hypersensitivity pneumonitis in adults. An official ATS/JRS/ALAT clinical practice guideline. Am J Respir Crit Care Med. (2020) 202:e36–69. 10.1164/rccm.202005-2032ST
31.
Salisbury ML Gu T Murray S Gross BH Chughtai A Sayyouh M et al . Hypersensitivity pneumonitis: radiologic phenotypes are associated with distinct survival time and pulmonary function trajectory. Chest. (2019) 155:699–711. 10.1016/j.chest.2018.08.1076
32.
Salvatore M Toussie D Pavlishyn N Yankelevitz D O'Connor T Henschke C et al . The right upper lobe bronchus angle: A tool for differentiating fibrotic and non-fibrotic sarcoidosis. Sarcoidosis Vasc Diffuse Lung Dis. (2020) 37:99–103. 10.36141/svdld.v37i2.8965
Summary
Keywords
progressive fibrosing interstitial lung disease, usual interstitial pneumonitis, nonspecific interstitial pneumonitis, hypersensitivity pneumonitis, sarcoidosis
Citation
Abu Qubo A, Capaccione KM, Bernstein EJ, Padilla M and Salvatore M (2022) The Role of Radiology in Progressive Fibrosing Interstitial Lung Disease. Front. Med. 8:679051. doi: 10.3389/fmed.2021.679051
Received
10 March 2021
Accepted
13 December 2021
Published
13 January 2022
Volume
8 - 2021
Edited by
Tejaswini Kulkarni, University of Alabama at Birmingham, United States
Reviewed by
Bridget Collins, University of Washington Medical Center, United States; Alpa Desai, Stony Brook Medicine, United States
Updates
Copyright
© 2022 Abu Qubo, Capaccione, Bernstein, Padilla and Salvatore.
This is an open-access article distributed under the terms of the Creative Commons Attribution License (CC BY). The use, distribution or reproduction in other forums is permitted, provided the original author(s) and the copyright owner(s) are credited and that the original publication in this journal is cited, in accordance with accepted academic practice. No use, distribution or reproduction is permitted which does not comply with these terms.
*Correspondence: Mary Salvatore ms5680@cumc.columbia.edu
This article was submitted to Pulmonary Medicine, a section of the journal Frontiers in Medicine
Disclaimer
All claims expressed in this article are solely those of the authors and do not necessarily represent those of their affiliated organizations, or those of the publisher, the editors and the reviewers. Any product that may be evaluated in this article or claim that may be made by its manufacturer is not guaranteed or endorsed by the publisher.